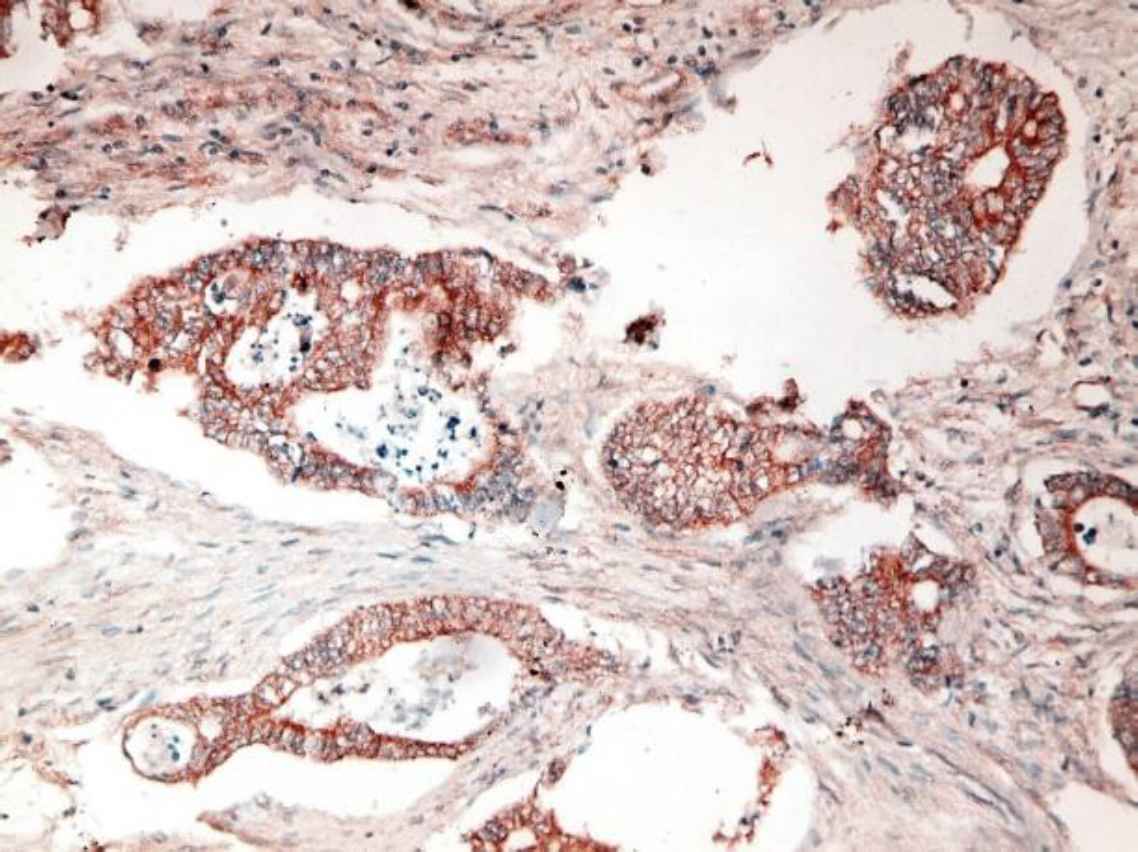
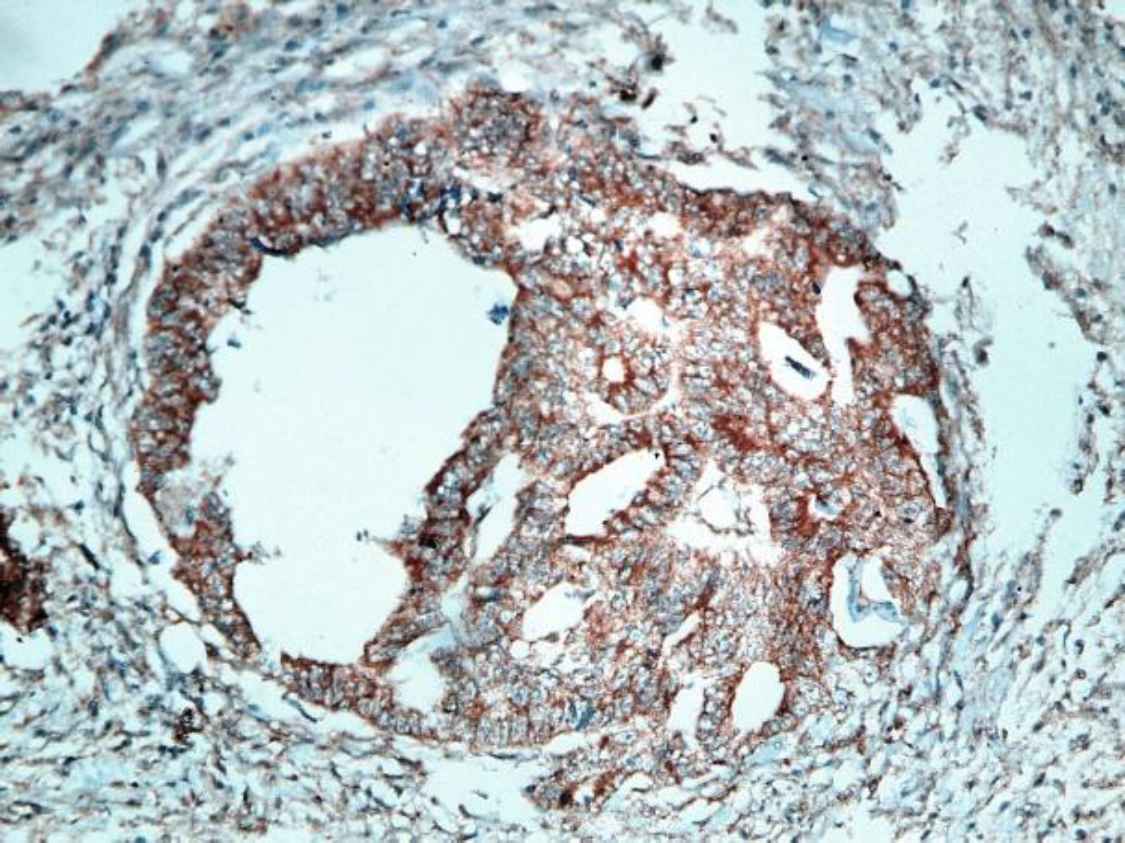

Introduction
Colorectal cancer (CRC) is the fourth most commonly diagnosed cancer and the 3rd most common cause of cancer death worldwide (1). It is also the 2nd most common cancer in females following breast cancer and the 3rd most common cancer in males following prostate and lung cancers (2).
The 5-year survival rate is 90% for the localized CRC, while CRC associated with lymph nodes or distant metastasis has a survival rate ranging from 14% to 71% (3). Tumor depth of invasion (T), lymph node status (N), tumor grade, and lymphatic and venous invasion are the most important histopathological prognostic factors (4), while clinical outcomes and patient survival are improved by screening programs and new treatment protocols, including targeted therapies. The main causes of patients’ mortality are local recurrence and distant metastasis (5). Therefore, the ability to predict the risk of both tumor aggressive local invasion and tumor metastasis can change and improve the clinical management of CRC patients.
Stanniocalcin 2 is a disulfide-linked homodimeric glycoprotein hormone formed of 302 amino acids and coded by STC2 gene on chromosome 5q35.2 (6) and is normally expressed in many human tissues, including proximal and distal convoluted tubules and collecting duct in the kidney, hepatocytes near central veins, alpha cells in the pancreas, adipose tissue, small and large intestine, smooth muscles, heart, spleen, lung, placenta, skeletal muscles, and brain (6,7).
Stanniocalcin 2 has many physiological functions, including calcium and phosphate homeostasis (8), osteoblast differentiation and mineralization (9), regulation of postnatal growth (10), angiogenesis and vascular sprouting in cases of hypoxia and ischemia (11), and protection against stress as it protects cells against apoptosis caused by insulting events such as oxidative stress, hypoxia, glucose deprivation, and endoplasmic reticulum stress through up-regulation of Cyclin-dependent kinase 2 and 4 (CDK2 and 4), down-regulation of cell cycle inhibitors p16 and p21, and activation of pAKT and pERK1/2 signaling pathway, which cause to increase cell viability and survival even after cell exposure to injurious stimuli (12)(13).
Stanniocalcin 2 over-expression is detected in various human cancers where it helps tumor cells to adapt to the stressful conditions in tumor microenvir-onment with hypoxia and glucose deprivation, thus increasing tumor ability to invade and progress. Recent studies indicated that STC2 was overexpressed in hepatocellular carcinoma, neuroblastoma, glioblastoma, renal cell carcinoma, esophageal squamous cell cancer, prostate, gastric, lung, head and neck, and ovarian cancers (14)(15), and high expression of STC2 in all above-mentioned tumors was correlated with the increased tumor growth, migration, invasion, increased incidence of nodal and distant metastasis, decreased survival and overall poor prognosis (6)(16). STC2 overexpression has been also reported in breast cancer, but is associated with a good prognosis (14)(17).
This study evaluated the level of STC2 immunohis-tochemical expression in 60 CRC cases and explored its association with different clinicopathological parame-ters.
Material and Methods
Tissue Collection
Sixty cases of colorectal cancer were retrospect-tively collected from archived paraffin blocks from Pathology Department, Faculty of Medicine, Cairo University. All specimens were obtained through colectomy procedure during the period between January 2018 and June 2019.
Routine Haematoxylin and Eosin (HE) staining
The staining was performed for the morphological analysis of the studied cases.
Immunohistochemical Staining
Tissue sections with 4 µm thickness were mounted on positively charged slides followed by routine de-paraffinization and antigen retrieval by citrate buffer (pH 6.0) in an automated water bath (Dako PT link, PT101), then, immunohistochemical staining was performed using anti-STC2 antibody (polyclonal rabbit anti-STC2 antibody IgG, 0.1 mL at 200 µg/mL purified by peptide affinity chromatography using Sulfo Link Coupling Resin, diluted at 1:50, manufactured by Thermo Fisher Scientific, U.S.A.) by an autostainer (Dako autostainer link 48) using a polymer-based detection system (Dako En Vision TM FLEX, K8000). The positive brown staining was visualized and photographed using a light microscope (BX51; Olympus Corporation, Tokyo, Japan).
STC2 staining score
STC2 staining score was calculated as introduced by Zhen-Hai Zhang et al., (18). The product of the percentage positivity of the stained tumor cells and the staining intensity were as follow; the percentage positivity <5%, scored 0; ≥5 to <25%, scored 1; ≥25 to <50%, scored 2; ≥50 to <75%, scored 3; and ≥75%, scored 4. Staining intensity was scored as score 0: no staining; score 1: mild staining; score 2: moderate staining; and score 3: strong staining.
The final STC2 immunostaining score ranges from 0 to 12 as follows: no expression (score of 0-3) and weak expression (score of 4-6) are considered negative STC2 expression, low-grade positive expression (+) (score of 7-9), and high-grade positive expression (++) (score of ≥10).
Statistical Analysis
The statistical analysis was performed using the SPSS version 16 (SPSS Inc., Chicago, IL. USA). Data were presented using descriptive statistics in the form of frequencies and percentages for the qualitative data and mean ± standard deviation (SD) for the quantitative variables. Chi-square test (X2) was used for the comparisons between STC2 expression subgroups. The level of statistical significance was set at probability P-value<0.05 (19).
Results
Of the 60 cases of CRC included in this study, 17 patients (28.33%) had negative STC2 staining (7 no staining and 10 weak staining, and both were considered negative according to our scoring system), 32 patients (53.33%) showed mild positive staining, and 11 patients (18.33%) demonstrated intense positive staining (Figure 1).
The association between the STC2 expression level and clinicopathological features was calculated by the Chi-squared test. Data are summarized in Table 1.
High STC2 expression in CRC tissues showed a statistically significant relation with histological tumor grade (P<0.001), tumor depth of invasion (T stage) (P=0.004), lymph node metastasis (N stage) (P=0.001), Dukes’ stage (P<0.001), lymphovascular invasion (P<0.001), and perineural invasion (P<0.001). There was no statistically significant association between the STC2 expression and other clinicopathological variables, such as gender (P=0.117), age (P=0.935), tumor location (P=0.249), tumor size (P=0.816), Gross appearance (P=0.139), and histological type (P=0.404).
Fig 1. a.Poorly differentiated CRC with intense positive cytoplasmic STC2 staining (IHC staining X40)
Fig 1. b.Moderately differentiated CRC with intense positive cytoplasmic STC2 staining (IHC staining X40)

Fig 1. c.Moderately differentiated CRC with mild positive cytoplasmic STC2 staining (IHC staining X400)

Fig 1. d.Moderately differentiated CRC with negative STC2 staining (IHC staining X20)
| Clinicopathological parameter | Number (%) | STC2 expression level | P-value | ||
|---|---|---|---|---|---|
| Negative | Mild positive | Intense positive | |||
| Gender | 0.117 | ||||
| Male | 30 (50) | 11 | 12 | 7 | |
| Female | 30 (50) | 6 | 20 | 4 | |
| Age | 0.935 | ||||
| ≥ 40 years | 46 (76.7) | 13 | 25 | 8 | |
| < 40 years | 14 (23.3) | 4 | 7 | 3 | |
| Tumor size, cm | 0.816 | ||||
| ≥ 5 cm | 33 (55) | 9 | 17 | 7 | |
| < 5 cm | 27 (45) | 8 | 15 | 4 | |
| Gross appearance | 0.139 | ||||
| Fungating | 26 (43.3) | 4 | 17 | 5 | |
| Ulcerating | 21 (35) | 10 | 7 | 4 | |
| Infiltrating | 13 (21.7) | 3 | 8 | 2 | |
| Tumor site | 0.249 | ||||
| Colon | 48 (80) | 13 | 24 | 11 | |
| Rectumand sigmoid | 12 (20) | 4 | 8 | 0 | |
| Histological type | 0.404 | ||||
| Adenocarcinoma | 58 (96.7) | 17 | 30 | 11 | |
| Mucinous | 2 (3.3) | 0 | 2 | 0 | |
| Tumor Grade | <0.001 | ||||
| Grade II | 54 (90) | 17 | 31 | 6 | |
| Grade III | 6 (10) | 0 | 1 | 5 | |
| Tumor T-Stage | 0.004 | ||||
| T2 | 3 (5) | 2 | 1 | 0 | |
| T3 | 46 (76.7) | 15 | 26 | 5 | |
| T4 | 11 (18.3) | 0 | 5 | 6 | |
| Lymph Node Metastasis | 0.001 | ||||
| N0 | 31 (51.7) | 13 | 16 | 2 | |
| N1 (1-3 regional L.N) | 17 (28.3) | 3 | 12 | 2 | |
| N2 (≥ 4 regional L.N) | 12 (20) | 1 | 4 | 7 | |
| Distant Metastasis | ---- | ||||
| Mx | 56 (93.3) | ||||
| M1 | 4 (6.7) | 0 | 0 | 4 | |
| Modified Dukes’ stage | <0.001 | ||||
| B1 | 1 (1.66) | 1 | 0 | 0 | |
| B2 | 30 (50) | 12 | 16 | 2 | |
| C1 | 1 (1.66) | 1 | 0 | 0 | |
| C2 | 24 (40) | 3 | 16 | 5 | |
| D | 4 (6.66) | 0 | 0 | 4 | |
| LVI | <0.001 | ||||
| Negative | 50 (83.3) | 17 | 30 | 3 | |
| Positive | 10 (16.7) | 0 | 2 | 8 | |
| PNI | <0.001 | ||||
| Negative | 52 (86.7) | 17 | 31 | 4 | |
| Positive | 8 (13.3) | 0 | 1 | 7 | |
Discussion
In Egypt, colorectal cancer is the 7th most commonly diagnosed cancer, representing 3.47% of cancers in males and 3% in females (20). It has a relatively high incidence at the age under 40 years (1.3/105). While the incidence in the age groups 40-59 years, 60-69 years and > 70 years are 12.0/105, 19.4/105 and 21.2/105, respectively (21).
Only a few studies previously focused on the STC2 expression in colorectal cancer and most of these studies were experimental or focused on DNA analysis (22-27). These studies indicated that STC2 gene silencing in CRC cells inhibits cell viability, invasion and migration, while STC2 over-expression increases EMT as it activates the phosphorylation of ERK, MEK and AKT signaling pathways, increases N-cadherin, vimentin and TWIST, decreases E-cadherin and upregulates P-glycoprotein. The STC2 also regulates the growth and migration of colon cancer cells under hypoxic conditions and reduces patients’ response to certain chemotherapeutic drugs.
To the best of our knowledge, only one recent study was performed to evaluate the immunohistochemical expression of STC2 in colon and rectal cancer and its relation to the tumor clinicopathological features by Zhang et al., and concluded that STC2 is an independent prognostic factor in colorectal cancer patients and the elevated STC2 expression is strongly correlated with the presence of nodal and distant metastasis, advanced clinical stage, and worse clinical outcome (15), and the results of this study was compared to that of Zhang et al., study.
In this study, STC2 was expressed in 71.7% of the 60 CRC cases (53.3% low grade positive +, and 18.3% high-grade positive ++) and 28.3% of the studied cases were STC2 negative. While in Zhang et al., study, negative STC2 expressions were found in 24.35% of the 115 cases included in their study and 75.6% of their cases expressed STC2 (15).
The STC2 expression in this work was intensely positive in 13.3% of the studied cases ≥ 40 years and in 5% of cases < 40 years old with no statistically significant relation between the STC2 expression and patients’ age (P=0.935). Also, intensely positive STC2 expression was detected in 23.3% of males and in 13.3% of females and there was no statistical relationship between the STC2 expression and the patients’ gender (P=0.117). Zhang et al. (15) showed in their work that high expression level of STC2 was found in 47.5% of males and 42.6% of females with no statistical relationship between the STC2 expression and the patients’ gender (P=0.595) and also found no statistically significant relation between the STC2 expression and the patients’ age (P=0.932).
Our study showed that 28.6% of lesions located in the ascending colon were intensely positive for STC2, and the majority of lesions located in the transverse, descending and sigmoid colon showed mild positivity for STC2 (75%, 68.8% and 63.6% of cases, respectively). Only 1 case of rectal cancer included in this study was intensely positive for the STC2. The relation between the STC2 expression and tumor site was statistically insignificant (P=0.249). In addition, no significant relationship was found between the STC2 expression and the tumor’s gross appearance (P =0.139). Zhang et al. (15) also found no statistically significant relation between the STC2 expression and tumor site (P=0.136) but with incidence rates of 51.6% of colon cancers and 37.7% of rectal cancers showing high expression of STC2. They did not demonstrate a relationship between the STC2 and the gross appearance of CRC.
This study showed no significant relationship between the STC2 expression and tumor size (P=0.816) or tumor histopathological type (P=Z0.404). The same results regarding tumor size were found by Zhang et al. (15). They did not express a relation between STC2 and tumor grade, while in this study, a statistically significant relation was found (P<0.001) between the previously mentioned variables.
According to Kim et al., tumor T stage is one of the five independent factors which affect overall survival in CRC patients (28) and tumor size is a significant prognostic and predictive factor especially for T1 colon cancer as large horizontal tumor extension is associated with poor prognosis (29).
The results of this study indicated a statistically significant relation between the STC2 expression and T stage (P=0.004). But in contrast to this result, Zhang et al., (15) found no significant relationship between the STC2 expression and tumor T stage (P=0.205).
Lymph node metastasis (N stage) is an important prognostic factor in the patients with CRC and a higher lymph nodes ratio (the ratio of the positive lymph nodes to the total lymph nodes harvested) is predictive for both overall and disease-free survival (30).
In this study, a statistically significant relation was found between the STC2 expression and tumor N stage (P=0.001). Zhang et al. (15) also reported a statistically significant relation between the STC2 expression and nodal metastasis.
A relation between the STC2 expression and distant metastasis could not be assessed in this study as 56 out of 60 studied cases were Mx and only 4 cases were identified as being associated with M1 stage and all 4 cases expressed high grade positive STC2 staining. Zhang et al. (15) found a statistically significant relation between the STC2 expression and distant metastasis (P=0.040) with high expression of STC2 in 70.6% of cases with distant metastasis and in 40.8% of cases without distant metastasis.
With regards to Dukes’ classification in this study, high grade positive STC2 expression was found in 100% of Dukes’ D stage (all 4 cases), 20.8% of Dukes’ C2 stage, and in 6.7% of Dukes’ B2 stage. Statistically significant relation was found between the STC2 expression and tumor Dukes’ stage (P<0.001).
According to Cienfuegos et al., perineural invasion is a major prognostic and predictive factor in colon cancer as PNI positive patients had a significantly lower disease-free survival at 5 years than patients without PNI (31) and both perineural invasion and lymphovascular invasion were associated with poorer disease-free survival and overall survival (32).
In this study, all cases with lymphovascular invasion were positive for the STC2 expression and a significant relation was found between the STC2 expression and lymphovascular invasion (P<0.001) and perineural invasion (P<0.001). Our results were different from Zhang et al. (15) results which stated no statistically significant relationship between the STC2 expression and lymphovascular invasion or perineural invasion.
A new emerging therapeutic role of STC2 in CRC has been expected and some recent studies aimed at testing this possibility.
A study by Miyazaki et al. in 2014 on immunohistochemical analysis of the STC2 expression levels in the patients with colorectal liver metastasis who underwent hepatectomy after receiving conven-tional chemotherapy with and without bevacizumab showed increased STC2 expression, which was higher in colorectal liver metastases treated with bevacizumab than patients without bevacizumab treatment. These data indicate that hypoxia-induced by anti-VEGF antibody therapy increases the STC2 expression and malignant potential of colorectal cancers and contributes to the treatment failure, which may explain the limited clinical effectiveness of anti-angiogenic agents (33).
It was recently discovered that STC2 gene silencing in the CRC cells inhibited cell viability, invasion and migration compared to the control cells. Meanwhile, E-cadherin increased, while vimentin, MMP-2 and MMP-9 decreased. These data showed that silencing STC2 treatment conferred a strong protective effect on CRC (34).
Conclusion
The STC2 immunohistochemical expression in cases of CRC may be strongly related to some clinicopathological para-meters including histological tumor grade, tumor depth of invasion, lymph node metastasis, tumor Dukes’ stage, the presence of lymphovascular invasion, and perineural invasion. These data suggest a potential role for the STC2 as a predictive biomarker for tumor aggression and behavior in the CRC patients. This study also had some limitations, such as small sample size and the inability to test for the familial CRC and microsatellite instability to correlate with the STC2 expression.
Ethics Approval
The study was approved by the Institutional Medical Ethical Committee.
Consent to Participate
Not applicable
Conflict of Interest
The authors declare that they have no competing interests.
Funding
The authors would like to confirm that they covered the expenses of this research work completely on their own and they were not funded by any institution in Egypt.
Authors' Contributions
The manuscript has been read and approved by all the authors
Category 1: a) Conception and design: 1st author. b) Analysis of data: All authors c) Interpretation of data: All authors Category 2: a) Drafting the article: All authors b) Revising it critically for important intellectual content: All authors Category 3: Final approval of the version to be published: All authors.
Acknowledgment
None.
References
- Rawla P, Sunkara T, Barsouk A. Epidemiology of colorectal cancer: incidence, mortality, survival, and risk factors. Prz Gastroenterol.. 2019; 14(2):89-103.
- Bray F, Ferlay J, Soerjomataram I, Siegel RL, Torre LA, Jemal A. Global cancer statistics 2018: GLOBOCAN estimates of incidence and mortality worldwide for 36 cancers in 185 countries [published correction appears in CA Cancer J Clin. CA Cancer J Clin. 2020; 70(4):313 -424.
- Siegel RL, Miller KD, Jemal A. Cancer statistics, 2019. CA Cancer J Clin.. 2019; 69(1):7-34.
- Zlobec I, Lugli A. Prognostic and predictive factors in colorectal cancer. Postgrad Med J.. 2008; 84(994):403-411.
- Siegel RL, Miller KD, Fedewa SA, Ahnen DJ, Meester RGS, Barzi A, Jemal A. Colorectal cancer statistics, 2017. CA Cancer J Clin.. 6; 67(3):177-193.
- Joshi AD. New Insights Into Physiological and Pathophysiological Functions of Stanniocalcin 2. Front. Endocrinol. 2020; 11:172.
- Joshi AD, Carter DE, Harper TA Jr, Elferink CJ. Aryl hydrocarbon receptor-dependent stanniocalcin 2 induction by cinnabarinic acid provides cytoprotection against endoplasmic reticulum and oxidative stress. J Pharmacol Exp Ther.. 2015; 353(1):201-12.
- Zeiger W, Ito D, Swetlik C, Oh-hora M, Villereal ML, Thinakaran G. Stanniocalcin 2 is a negative modulator of store-operated calcium entry. Mol Cell Biol.. 2011; 31(18):3710-22.
- Zhou J, Li Y, Yang L, Wu Y, Zhou Y, Cui Y, Yang G, Hong Y. Stanniocalcin 2 improved osteoblast differentiation via phosphorylation of ERK. Mol Med Rep. 2016; 14:5653-5659.
- Jepsen MR, Kløverpris S, Bøtkjær JA, Wissing ML, Andersen CY, Oxvig C. The proteolytic activity of pregnancy-associated plasma protein-A is potentially regulated by stanniocalcin-1 and -2 during human ovarian follicle development. Hum Reprod.. 2016; 31(4):866-874.
- Law AY, Wong CK. Stanniocalcin-1 and -2 promote angiogenic sprouting in HUVECs via VEGF/VEGFR2 and angiopoietin signaling pathways. Mol Cell Endocrinol.. 15; 374(1-2):73-81.
- Ito D, Walker JR, Thompson CS, Moroz I, Lin W, Veselits ML et al. Characterization of stanniocalcin 2, a novel target of the mammalian unfolded protein response with cytoprotective properties. Mol Cell Biol.. 2004; 24(21):9456-69.
- Kim PH, Na SS, Lee B, Kim JH, Cho JY. Stanniocalcin 2 enhances mesenchymal stem cell survival by suppressing oxidative stress. BMB Rep.. 2015; 48(12):702-707.
- Hou J, Wang Z, Xu H, Yang L, Yu X, Yang Z. Stanniocalicin 2 suppresses breast cancer cell migration and invasion via the PKC/claudin-1-mediated signaling. PLoS ONE.. 2015; 10(4):e0122179.
- Zhang C, Chen S, Ma X, Yang Q, Su F, Shu X et al. Upregulation of STC2 in colorectal cancer and its clinicopathological significance. Onco Targets Ther.. 2019; 15(12):1249-1258.
- Wang Y, Wu J, Xu J, Lin S. Clinical significance of high expression of stanniocalcin-2 in hepatocellular carcinoma. Biosci Rep.. 26; 39(4):BSR20182057.
- Todd JR, Ryall KA, Vyse S, Wong JP, Natrajan RC, Yuan Y et al. Systematic analysis of tumour cell-extracellular matrix adhesion identifies independent prognostic factors in breast cancer. Oncotarget.. 2016; 7(39):62939-62953.
- Zhang ZH, Wu YG, Qin CK, Rong ZH, Su ZX, Xian GZ. Stanniocalcin 2 expression predicts poor prognosis of hepatocellular carcinoma. Oncol Lett.. 2014; 8(5):2160-2164.
- Dawson B, Trapp R. Basic and Clinical Biostatistics, 4 th Edition, New York, United States. Mcgraw-Hill Medical Publishing Inc; 2004.
- Ibrahim AS, Khaled HM, Mikhail NN, Baraka H, Kamel H. Cancer incidence in Egypt: results of the national population-based cancer registry program. J Cancer Epidemiol. 2014;437971.
- Veruttipong D, Soliman AS, Gilbert SF, Blachley TS, Hablas A, Ramadan M. et al. Age distribution, polyps and rectal cancer in the Egyptian population-based cancer registry. World J Gastroenterol.. 2012; 18(30):3997-4003.
- Ieta K, Tanaka F, Yokobori T, Kita Y, Haraguchi N, Mimori K. Clinicopathological significance of stanniocalcin 2 gene expression in colorectal cancer. Int. J. Cancer.. 2009; 125:926-931.
- Miyazaki S, Kikuchi H, Iino I, Uehara T, Setoguchi T, Fujita T. Anti‐VEGF antibody therapy induces tumor hypoxia and stanniocalcin 2 expression and potentiates growth of human colon cancer xenografts. Int. J. Cancer. 2014; 135:295-307.
- Yuan Q, Zhan L, Zhang LL, Wang Q, Liu J, Jiang ZY et al. Stanniocalcin 2 induces oxaliplatin resistance in colorectal cancer cells by upregulating P-glycoprotein. Can J Physiol Pharmacol.. 2016; 94(9):929-35.
- Chen B, Zeng X, He Y, Wang X, Liang Z, Liu J et al. STC2 promotes the epithelial-mesenchymal transition of colorectal cancer cells through AKT-ERK signaling pathways. Oncotarget.. 2016; 7(44):71400-71416.
- Chen X, Liu Q, Huang W, Cai C, Xia W, Peng Y et al. Stanniocalcin-2 contributes to mesenchymal stromal cells attenuating murine contact hypersensitivity mainly via reducing CD8+ Tc1 cells. Cell Death Dis. 2018; 9(5):548.
- Li Q, Zhou X, Fang Z, Pan Z. Effect of STC2 gene silencing on colorectal cancer cells. Mol Med Rep. 2019; 20:977-984.
- Kim MS, Park EJ, Kang J, Min BS, Lee KY, Kim NK et al. Prognostic factors predicting survival in incurable stage IV colorectal cancer patients who underwent palliative primary tumor resection. Retrospective cohort study. Int J Surg.. 2018; 49:10-15.
- Dai W, Mo S, Xiang W, Han L, Li Q, Wang R et al. The Critical Role of Tumor Size in Predicting Prognosis for T1 Colon Cancer. Oncologist.. 2020; 25(3):244-251.
- Kim HJ, Choi GS. Clinical Implications of Lymph Node Metastasis in Colorectal Cancer: Current Status and Future Perspectives. Ann Coloproctol.. 2019; 35(3):109-117.
- Cienfuegos JA, Martínez P, Baixauli J, Beorlegui C, Rosenstone S, Sola JJ et al. Perineural Invasion is a Major Prognostic and Predictive Factor of Response to Adjuvant Chemotherapy in Stage I-II Colon Cancer. Ann Surg Oncol.. 2017; 24(4):1077-1084.
- Sun Q, Liu T, Liu P, Luo J, Zhang N, Lu K et al. Perineural and lymphovascular invasion predicts for poor prognosis in locally advanced rectal cancer after neoadjuvant chemoradiotherapy and surgery. J Cancer.. 2019; 21;10(10):2243-2249.
- Miyazaki S, Kikuchi H, Iino I, Uehara T, Setoguchi T, Fujita T et al. Anti-VEGF antibody therapy induces tumor hypoxia and stanniocalcin 2 expression and potentiates growth of human colon cancer xenografts. Int J Cancer.. 2014; 135(2):295-307.
- Li Q, Zhou X, Fang Z, Pan Z. Effect of STC2 gene silencing on colorectal cancer cells. Molecular medicine reports.. 2019; 20(2):977-84.

